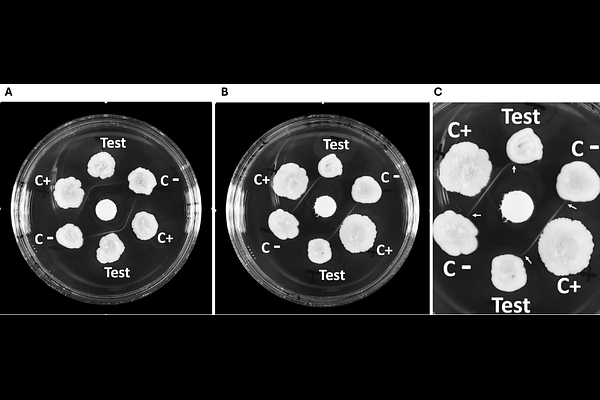
Poster

Modified Elek test improves in-vitro detection of diphtheria toxin
Modified Elek test improves in-vitro detection of diphtheria toxin
Badell-Ocando, E.; Bremont, S.; Barbet, M.; Passet, V.; Crestani, C.; Brisse, S.
AbstractPurpose: Diphtheria is caused by toxigenic strains of the Corynebacterium diphtheriae complex, mainly Corynebacterium diphtheriae and C. ulcerans. The diagnosis of diphtheria relies on detecting the diphtheria toxin (DT), for which Engler method of Elek immunoprecipitation test is the gold standard. A recent optimization of Engler method was proposed by Melnikov and colleagues, showing higher sensitivity for C. ulcerans. The goal of our study was to test and adapt this optimized method, and to re-analyze apparent non-toxigenic tox gene bearing (NTTB) isolates from our collection. Methods: We included 48 C. ulcerans, C. ramonii and C. diphtheriae isolates previously categorized as NTTB but for which no genetic explanation was found for the lack of DT expression. DT production was tested using Melnikov method with further modifications made by us: i) increasing the antitoxin concentration; ii) using 5 degrees Celsius as the incubation temperature after 24h; and iii) modifying the layout of control and test strains on agar plates. Results: 35 of 38 C. ulcerans, 3 C. ramonii and 8 of 10 C. diphtheriae were found to be toxigenic. No genetic explanation was found regarding two non-toxigenic isolates (1 C. diphtheriae and 1 C. ulcerans), whereas for one C. diphtheriae, IS1132 was detected upstream of the tox gene. Conclusion: Our modified implementation of Melnikov Elek test improved our ability to detect diphtheria toxin production. Most isolates previously considered as NTTB but with no genetic explanation, were shown to be toxigenic using the novel method.